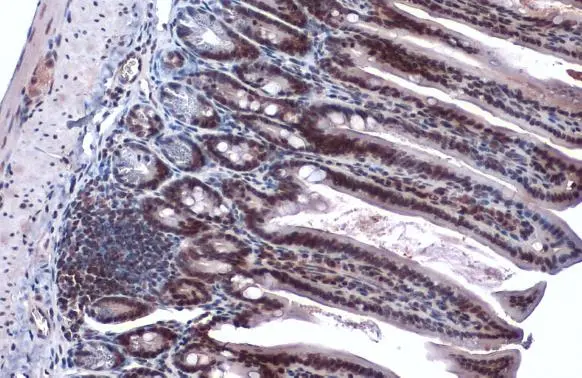
EP300 antibody detects EP300 protein at nucleus by immunohistochemical analysis. Sample: Paraffin-embedded mouse intestine. EP300 stained by EP300 antibody (GTX134238) diluted at 1:1000. Antigen Retrieval: Citrate buffer, pH 6.0, 15 min

EP300 antibody detects EP300 protein at nucleus by immunohistochemical analysis. Sample: Paraffin-embedded mouse stomach. EP300 stained by EP300 antibody (GTX134238) diluted at 1:1000. Antigen Retrieval: Citrate buffer, pH 6.0, 15 min
EP300 antibody
GTX134238
ApplicationsWestern Blot, ImmunoHistoChemistry, ImmunoHistoChemistry Paraffin
Product group Antibodies
ReactivityHuman, Mouse
TargetEP300
Overview
- SupplierGeneTex
- Product NameEP300 antibody
- Delivery Days Customer9
- Application Supplier NoteWB: 1:500-1:3000. *Optimal dilutions/concentrations should be determined by the researcher.Not tested in other applications.
- ApplicationsWestern Blot, ImmunoHistoChemistry, ImmunoHistoChemistry Paraffin
- CertificationResearch Use Only
- ClonalityPolyclonal
- Concentration1.29 mg/ml
- ConjugateUnconjugated
- Gene ID2033
- Target nameEP300
- Target descriptionEP300 lysine acetyltransferase
- Target synonymsKAT3B, MKHK2, RSTS2, p300, histone acetyltransferase p300, E1A binding protein p300, E1A-associated protein p300, E1A-binding protein, 300kD, histone butyryltransferase p300, histone crotonyltransferase p300, p300 HAT, protein 2-hydroxyisobutyryltransferase p300, protein lactyltransferas p300, protein propionyltransferase p300
- HostRabbit
- IsotypeIgG
- Protein IDQ09472
- Protein NameHistone acetyltransferase p300
- Scientific DescriptionThis gene encodes the adenovirus E1A-associated cellular p300 transcriptional co-activator protein. It functions as histone acetyltransferase that regulates transcription via chromatin remodeling and is important in the processes of cell proliferation and differentiation. It mediates cAMP-gene regulation by binding specifically to phosphorylated CREB protein. This gene has also been identified as a co-activator of HIF1A (hypoxia-inducible factor 1 alpha), and thus plays a role in the stimulation of hypoxia-induced genes such as VEGF. Defects in this gene are a cause of Rubinstein-Taybi syndrome and may also play a role in epithelial cancer. [provided by RefSeq, Jul 2008]
- ReactivityHuman, Mouse
- Storage Instruction-20°C or -80°C,2°C to 8°C
- UNSPSC41116161